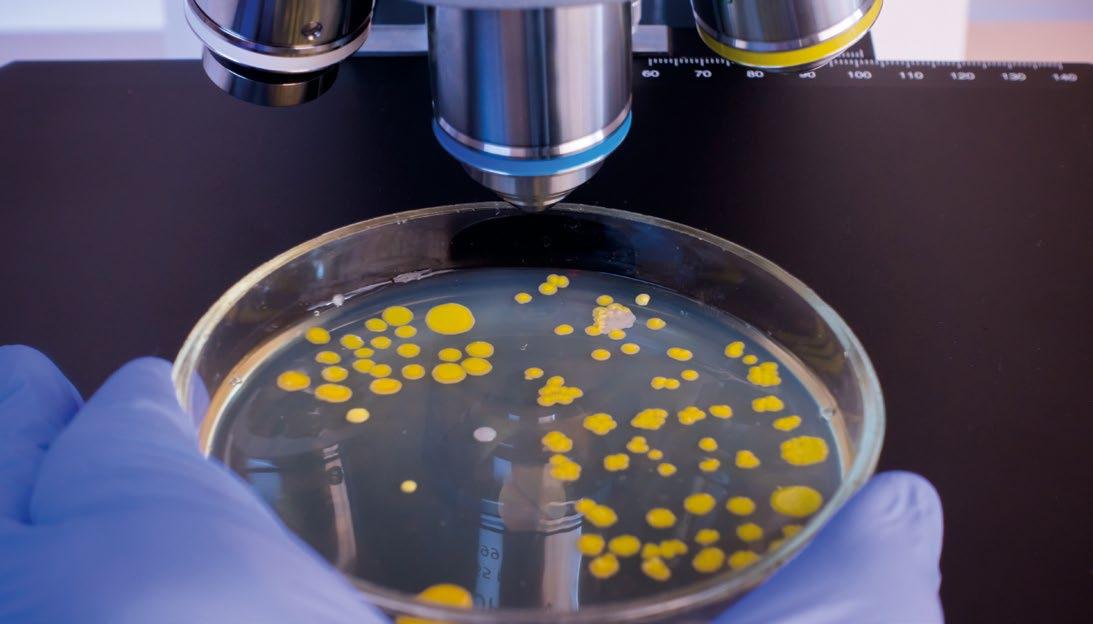

12 minute read
Food rules DIRITTO ALIMENTARE
Controperizia e controversia
Second expert opinion and dispute
Advertisement
di Giuseppe Maria Durazzo
Avvocato esperto in diritto dell’alimentazione
The article illustrates the issues related to the dispute and second expert opinion for the operator who, as a result of the latter, does not agree with the assessments given by the competent authority regarding the non-conformity of a product. In fact, the latter will be able to activate the dispute procedure, within the mandatory term of thirty days from the receipt of the communication of the unfavourable outcome, requesting the competent authorities to carry out, at his/ her own expenses, the review of the documentation relating to the analysis, test or initial diagnosis by the Istituto Superiore di Sanità (ISS). According to the author, this procedure presents a certain number of problems, first and foremost the additional bureaucratisation of the matter. A un anno dall’entrata in vigore del D.Lgs. 2021/27, che adegua la normativa italiana al Regolamento (Ue) 625/2017 in materia di reati alimentari e nuovo regime dei controlli ufficiali, è opportuno ragionarne anche nell’ottica degli sfortunati attori che, come operatori del settore alimentare o controllori ufficiali, si imbattono nella procedura che tale norma ha innovato. Tralasciando la fase del prelevamento del campione di alimento da analizzare e gli adempimenti in capo all’operatore per il controllo, la nuova procedura, a seguito di esito sfavorevole
LA PROCEDURA E IL DIRITTO ALLA DIFESA
THE PROCEDURE AND THE RIGHT OF DEFENCE
delle analisi, si articola in alcuni passi che qui ripercorro: a) il laboratorio ufficiale comunica all’autorità competente il risultato della prova, dell’analisi o della diagnosi; b) l’autorità competente procede alla valutazione del risultato e la comunica alle parti interessate, quindi all’impresa alimentare. In realtà, in una nota regionale si legge che la valutazione spetti all’autorità competente che ha effettuato il campionamento, mentre il testo della norma riserva all’autorità competente la valutazione del risultato ottenu-




to dal laboratorio ufficiale (art. 7, punto 4). Questione che non è solo procedurale ma sostanziale, visto che l’esito del controllo non può manifestarsi solo con un dato, ad esempio, numerico, ma attraverso la valutazione scientifico-legale del risultato ottenuto. Con ciò, a mio avviso, si ristabilisce un corretto processo di valutazione che, talvolta, in passato, era stato tralasciato. In caso di esito sfavorevole, l’impresa alimentare può chiedere una controperizia, a cura di un esperto qualificato, che consiste nell’esame documentale delle registrazioni inerenti le attività condotte dal momento del campionamento fino all’emissione del rapporto di prova relativo alla singola analisi, prova o diagnosi, ma anche l’esecuzione a proprie spese presso un laboratorio accreditato di fiducia dell’analisi, prova o diagnosi eseguita sull’aliquota eventualmente resa disponibile al momento del campionamento. L’impresa alimentare può chiedere, a proprie spese, che l’autorità competente compia un esame documentale delle operazioni effettuate dell’organo di controllo. Per depositare la domanda, l’operatore alimentare ha 15 giorni dal ricevimento dalla comunicazione dell’esito sfavorevole.

La controperizia
Si nota che il chiedere la controperizia, ex art. 7 della norma, sia un diritto di fatto sottoposto alla condizione di avere, dall’organo di controllo, le informazioni delle non conformità, ma anche copia della documentazione da esaminare con il proprio esperto e del campione da eventualmente sottoporre all’analisi. La norma non sembra prevedere esplicitamente che il termine dei 15 giorni per chiedere la controperizia si perfezioni dal ricevimento della documentazione esaminanda proveniente dall’autorità di controllo. Il che evidenzia una fragilità regolatoria che, da un lato, impone alla parte un termine (breve) per esercitare il diritto alla controperizia e, dell’altro, non prevede, e neppure (apparentemente) tollera, lo slittamento dello stesso in funzione dei tempi necessari all’azienda per chiedere la documentazione, all’autorità per fornirla e men che meno che la procedura possa incappare in qualche ritardo ingiustificato o mancata risposta da parte della pubblica amministrazione. Insomma, pensare che l’azienda alimentare possa presentare domanda di controperizia avendo, nei 15 giorni precedenti, chiesto, ottenuto e studiato la documentazione da cui trarre la decisione di sollecitare la controperizia, appare particolarmente e ingiustamente gravoso come carico imposto per l’esercizio del diritto di difesa e privo di bilanciamento rispetto agli obblighi dell’autorità di controllo. Salvo ipotizzare che l’azienda controllata possa chiedere il riesame documentale all’autorità competente senza aver conoscenza degli atti, insomma alla cieca; condizione che parrebbe comunque censurabile, non meno di una procedura

in cui l’esercizio del diritto sia sottoposto, apparentemente a pena di decadenza, alla tempestività del comportamento dell’amministrazione alla quale, peraltro, non è imposto alcun termine. Si noti che la controperizia è soggetta al pagamento di una tariffa.
La controversia
L’autorità di controllo (“competente”) comunica l’esito della controperizia al soggetto controllato, il quale può attivare la “controversia”, ex art. 8 della norma, entro 30 giorni dal ricevimento della comunicazione di non conformità, nel caso non condivida le valutazioni dell’autorità. La controversia consiste, in una prima fase, nel riesame della documentazione relativa all’analisi, prova o diagnosi da parte dell’Istituto Superiore di Sanità. Anche questa fase sarà a spese del richiedente. La domanda della fase di controversia comporta la motivazione della domanda. All’esito della valutazione della documentazione da parte dell’Istituto Superiore di Sanità, l’operatore alimentare può chiedere allo stesso Istituto, entro 30 giorni, un’altra analisi, prova o diagnosi. Anche in questo caso l’attività è a pagamento. L’Istituto Superiore di Sanità notifica entro 60 giorni l’esito della ripetizione della prova.
LA CONTROVERSIA CONSISTE NEL RIESAME DELLA DOCUMENTAZIONE DELL’ANALISI
Una diversa procedura, in accordo con il comma 3, dell’art. 3, del D.Lgs. 23/2021, è prevista nel caso di campionamenti, analisi, prove o diagnosi su animali e merci provenienti da altri Stati membri. In tal caso, gli UVAC e i servizi veterinari delle aziende sanitaria competenti per materia e territorio applicano, per quanto riguarda il diritto dell’operatore a una controperizia, quanto disposto dall’art. 35 del Reg. (Ue) 2017/625, come chiarito con protocollo n. 435/2021/P/401-404 del Ministero della Salute UVAC-PIF di Veneto, FriuliVenezia Giulia e Trentino-Alto Adige.



Le criticità della norma e della procedura
Per tornare alla disposizione di cui al D.Lgs. 2021/27, essa crea una contrapposizione tra organo di controllo e azienda alimentare invece di fornire un legittimo metodo di verifica della prova eseguita dal primo laboratorio e del conseguente giudizio. La controperizia, eseguita per giunta dalla stessa autorità di controllo competente sul proprio operato e su quello del laboratorio designato all’esame, appare un passaggio che pone la pubblica amministrazione nella spiacevole condizione di autovalutare il proprio operato a seguito di una specifica sollecitazione (la controperizia) da parte del controllato. La previsione appare inopportuna in quanto, in via generale, è dovere della pubblica amministrazione correggere i propri errori e tale istituto giuridico che si concretizza nell’obbligo di autotutela è applicabile anche alle fattispecie ricadenti nell’art. 7 del D.Lgs. 2021/27: l’obbligo di autotutela può essere sollecitato attraverso il ricorso in autotutela da attivarsi a cura del soggetto controllato, il quale ha la facoltà di proporlo in ogni momento, mentre in base all’art. 7 è una fase procedurale ineliminabile (quindi condizione necessaria), con tempi e modi specifici, se si voglia procedere e ottenere la ripetizione dell’analisi da parte di un diverso laboratorio. Quindi, la procedura della controperizia costituisce, nell’apparente specialità della norma, un inutile e quindi dannoso aumento della procedura amministrativa che, già dalle definizioni utilizzate dal Legislatore (controperizia e controversia), sembra doversi muovere sullo sviluppo di ipotesi antitetiche e contrapposte, e non semplicemente di approfondimento e verifica, per giungere a un accertamento di migliore e confermata qualità con i normali requisiti di imparzialità, terzietà, competenza tecnica e contraddittorio tra le parti. Non appare, almeno dal testo della norma, possibile evitare uno o più passaggi della pro-
LA NUOVA PROCEDURA NON PERMETTE IL CONFRONTO DIRETTO FRA TECNICI PUBBLICI E DELL’AZIENDA


cedura (che possono essere ben quattro) per arrivare a chiedere quello che normalmente è il cuore di una verifica di conformità, vale a dire la nuova analisi effettuata in un competente e diverso laboratorio d’analisi. Nel novellato sembra preferirsi un approccio prevalentemente valutativo piuttosto che analitico, quasi che una valutazione non dovesse fondarsi su dati ottenuti nelle migliori e provate condizioni tecniche e di diritto di difesa. I diversi passaggi a scaletta potrebbero anche porre la questione, giuridicamente centrale, se l’amministrazione, nelle sue diverse articolazioni coinvolte nella procedura di cui agli artt. 7 e 8 della norma, possa rifiutare la domanda che l’azienda alimentare oggetto del controllo ha facoltà di proporre. Se cioè il parere negativo (il non accoglimento della tesi difensiva) espresso dall’amministrazione nella fase della controperizia o in quella della controversia, ne produca l’estinzione e l’ablazione del diritto di difesa. Se quindi prevalga la decisione amministrativa sulla previsione, a quel punto solo ipotetica, di una serie di atti di difesa, non più di diritti, previsti dal Legislatore a tutela del soggetto controllato.
No al confronto diretto
Se tra gli scopi della norma vi era quello deflattivo, il dilatarsi dei passaggi della procedura ha prodotto un’ipertrofia di atti, trasmissione di documenti e aumento di spesa che può indurre a rinunciare al proprio diritto difesa non per la capacità del nuovo sistema di dare risposte adeguate, ma per il fatto di rendere non conveniente, defatigante e, in concreto, non agibile un processo che per fattispecie sanzionate in misura minore o contestate ad attività economiche che abbiamo difficoltà a sostenere spese di consulenti e di analisi (documentali e non), può risultare diseconomico. Tra le criticità della procedura occorre annoverare il fatto che vi sono situazioni nelle quali la non conformità può portare a contestazioni di ordine penale non necessariamente evidenti all’inizio della ricerca dell’eventuale non conformità dell’alimento. Ciò introduce l’ulteriore e fondamentale elemento procedurale che è opportuno evidenziare. La nuova procedura, seppure nella sua ricca articolazione, non permette un confronto diretto tra le opinioni dei tecnici del controllo ufficiale e quelli dell’azienda, creando una sfasatura temporale tra le fasi di attività di una parte e dell’altra e senza che l’operatore alimentare possa partecipare, e quindi collaborare anche esercitando il diritto di partecipazione a propria tutela, alla formazione dell’esito dell’accertamento tecnico che si sviluppa nella fase dell’accertamento amministrativo o preprocessuale. L’esistenza della criticità pare confermata anche da talune circolari. Ad esempio, nella circolare 9 aprile 2021, prot. 0163828, della Regione Veneto, ove si legge che, al fine di evitare conteziosi, per le contestazioni di natura penale si continuano ad applicare le disposizioni previste dal DPR 327/1980 (in tal senso anche la nota di ALISA Regione Liguria, n. 0014032 del 12 aprile 2021). E anche nel caso di ricerca di pericoli in matrici per cui non sia assicurata la riproducibilità, ai sensi dell’art. 7, comma 2 del primo periodo del D.Lgs. 27/2021, “al fine di garantire la difesa in sede penale, a questi campioni si applicano le disposizioni previste nel comma 1, art. 223, del D.Lgs. n. 271 del 1989”.
Serve una norma “ponte”
Se anche alla fase di controversia, con ripetizione di analisi da parte dell’Istituto Superiore di Sanità, si applica la procedura prevista nel comma 2, art. 223, del D.Lgs. 271/1989 (come si legge nella sopra citata circolare della Regione Veneto), ne traggo la conclusione che la procedura di cui al D.Lgs. 2021/27 in realtà non sia valida nel caso di potenziale violazione sanzionabile penalmente, a meno che detta procedura offra contestualmente le garanzie previste dalla norma di coordinamento del Codice di procedura penale. In mancanza di una norma “ponte” tra procedure diverse, la legalità di una procedura, creata dagli stessi operatori amministrativi secondo l’indirizzo fornito dalle circolari sopra citate e che misceli gli elementi di due norme diverse con regole diverse, non pare che possa raggiungersi con un semplice miglioramento dei formulari standard utilizzati dall’amministrazione, visto che il potenziale responsabile della violazione deve essere in grado di sapere, fin dall’inizio, se la difesa da approntarsi sia per una possibile violazio-

ne amministrativa o invece penale. L’operatore alimentare deve potersi difendere, secondo criteri conformi al diritto di difesa, fin dalle prima battute dell’atto di indagine. Mi pare di difficile negabilità che il vuoto normativo creato dell’ipertrofica novella procedura di controperizia e controversia privi di legalità specialmente le non conformità che possono essere sanzionate in via penale. Il che sarebbe (apparentemente) coerente con la prima pubblicazione del D.Lgs. 2021/27, che abrogò l’art. 5 della L. 283/62, salva la modifica che annullò l’abrogazione prima ancora che il D.Lgs. si applicasse. Senza affrontare il tema nel suo complesso, ma quale conferma della trasversalità dei vizi nella novella, va notato come anche in materia di campionamento si ponga nuovamente il tema della legalità rispetto ai diritti di difesa. La circolare del Ministero della Salute n. 0019604 dell’11 maggio 2021 così si esprime: “Al fine di evitare contenziosi tra le autorità competenti e gli operatori economici del settore alimentare dovuti alla differente garanzia del diritto alla difesa espressa nel Reg. (Ue) 2017/625, esplicitata negli artt. 7 e 8 del D.Lgs. n. 27/2021, rispetto alla normativa nazionale in materia penale, per l’attività di campionamento si applicano le disposizioni previste dal DPR 327/80”.
Riflessioni finali
Anche tralasciando diversi argomenti correlati alla legalità della procedura, ad esempio in tema di potenziali conflitti di interessi dei laboratori ufficiali coinvolgibili nella procedura, o quello dei metodi analitici utilizzabili, nell’applicazione nazionale sembra essersi perso di vista, almeno parzialmente, che il controllo degli alimenti possa avere lo scopo di un monitoraggio, piuttosto che di un controllo ai fini legali, determinando gli effetti giuridici che diverse norme di settore prevedono (si pensi al sistema delle gestione delle non conformità, piuttosto che a quello di verifica degli alimenti non sicuri o sicuri ma non conformi a taluni requisiti di legge, ad esempio, in tema di composizione, origine ecc.). Dunque, se da un lato l’autorità sanitaria mira, con la propria azione, ad aumentare il livello di tutela della salute pubblica, l’esito del controllo dell’alimento può costituire un fatto presupposto dell’azione sanzionatoria amministrativa o di un processo penale che debbono garantire non la pena ma il giusto procedimento amministrativo conoscitivo, valutativo e di eventuale irrogazione della sanzione o, nel caso, il giusto processo. L’aver calato una norma d’interesse principalmente sanitario, come quella prevista dal Reg. (Ue) 2017/625, all’interno di un sistema giuridico nazionale italiano fortemente improntato al contrasto delle violazioni attraverso l’applicazione di sanzioni, ha determinato la distorsione di un metodo di lavoro senza un pieno adattamento alle esigenze nazionali in tema di legalità. L’evidenza, a chi scrive, delle gravi carenze giuridiche della procedura brevemente esaminata, non può che condurre, oltre all’inevitabile richiesta di riforma del testo normativo, all’invito a esercitare il diritto di difesa nelle sedi e con gli strumenti di legge, anche a fronte della novella procedura che troverà, nel tempo, l’inevitabile censura.
Giuseppe Maria Durazzo
